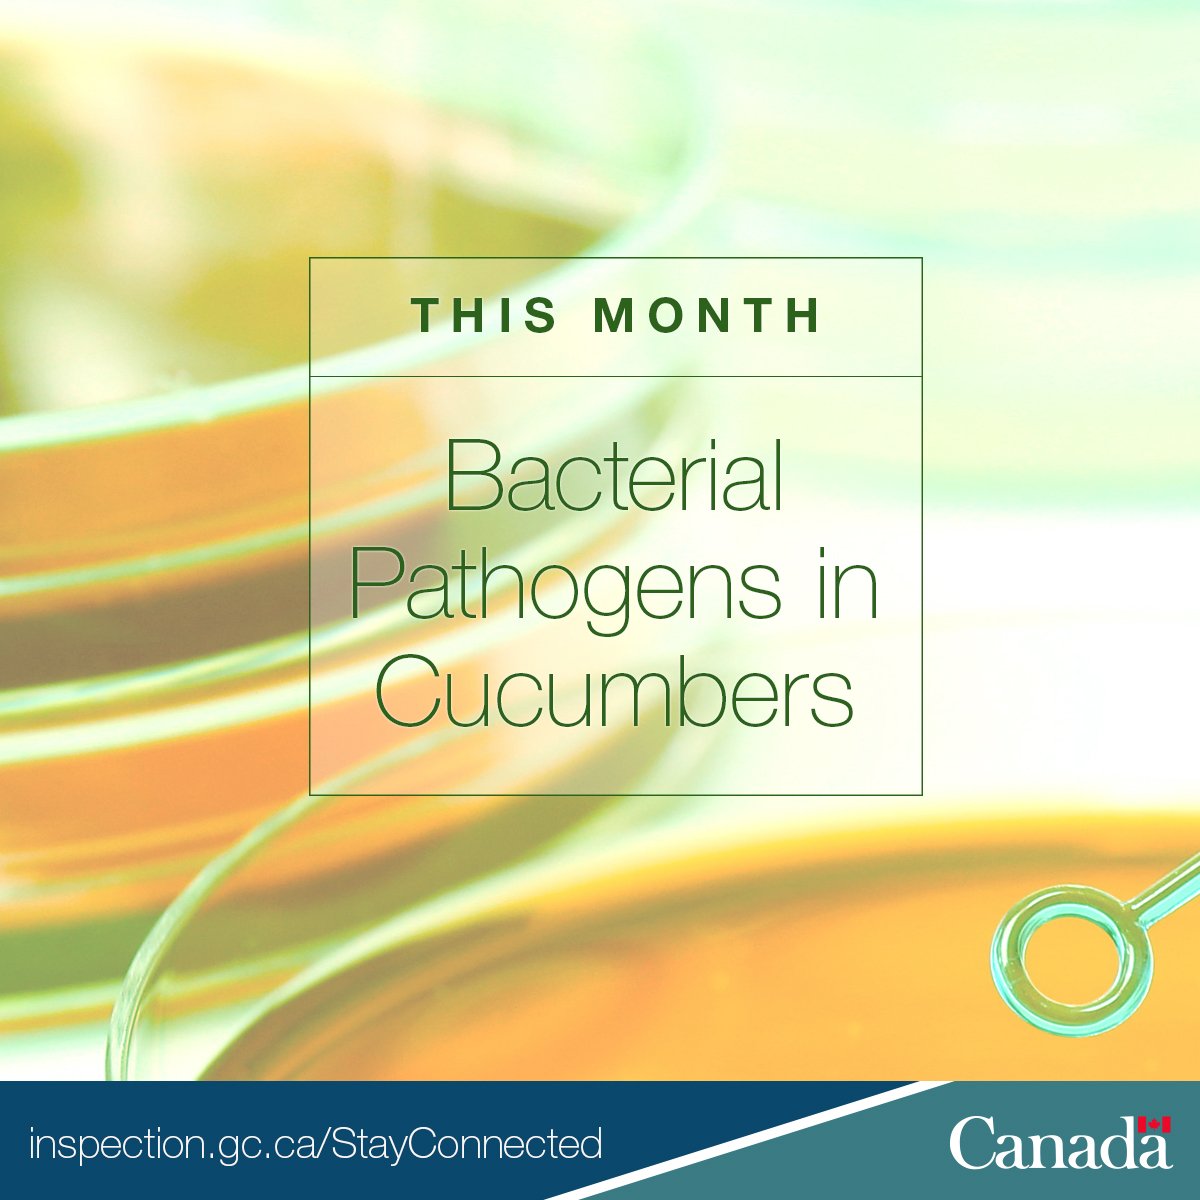
InspectionCan's tweet image. The #CFIABulletin for March is now available! #OpenGovCan ow.ly/FmjU30j4UbY

#opengovcan search results
You have no idea how proud I am of watching the #CanadaBeyond150 #opengovcan team present to their managers. Dans les deux langues en plus. This is what the next generation of public leaders look like:Open, inclusive, and curious! #proudpapa

This is what success looks like. #CanadaBeyond150 #opengovcan team, conversing about the dynamic of navigating citizen engagement complicated by chatbots and troll factories with deputies and @Clerk_GC

Join us in congratulating CIGI’s @biancawylie on her Open City Champions Award, recognizing her leadership in Toronto's open data community. #OpenGovWeek #OpenGovCan cc: @PSDintelligence @ODItoronto @CivicTechTO

Just packed up a 16+ year stint at @TBS_Canada having led strategic communications, media relations, #OpenGovCan files, and #OCHRO people management initiatives. Worked with and for incredible people. Starting soon at @AANDC_AADNC in StratComms!

In February's #CFIABulletin, we tested for viruses in sun-dried tomatoes. #OpenGovCan ow.ly/jbRF30iDX78

Canada’s innovators in #tech play an important role in sustaining our prosperity in today's digitally driven global economy. We are proud to be supporting them to access global markets and find international partners! #OGPCanada #OpenGovCan

I am happy to deliver a Roadmap for Open Science to bolster the Government of Canada’s efforts in making federal science open and accessible to all! Read more about it: canada.ca/en/innovation-… #OpenScience #OpenGovCan

Excited to see the collaboration at workshops to increase proactive publication across government #OpenGovCan Ravi de voir la collaboration lors des ateliers pour accroître la publication proactive àl’échelle du gouvernement #gouvertCan

Why test for Listeria monocytogenes in ready-to-eat (RTE) products? #CFIABulletin #OpenGovCan ow.ly/hUFC30iDX6O

The 2017 financial summaries on the Canadian broadcasting sector are now available on the #OpenData portal! #OpenGovCan ow.ly/O35N30kRDfC

Making government information and data available to citizens is a #GC priority. Read my #ClerkReport to learn about some of these efforts that have made Canada a world leader in open government #OpenGovCan ow.ly/m24O30jG3O0
Go team! The #opengovcan team is giving an overview of the #OGPCanada Summit to #GCdigital colleagues. Such great opportunities to explore the future of open, digital gov.

People don't really latch on to #OpenGov - it's more about citizen engagement, government accessibility accountability and participation #OpenGovCan

#OpenGovWeek is a unique opportunity for Canadians to influence how government interacts with its citizens. Have your say by getting involved! Find out how: open.canada.ca/en/content/ope… #OpenGovCan

Join the conversation on how citizens, civil society and government can better work together during #OpenGovWeek. See what Canada’s planning from May 7-11 by viewing the event calendar here: ow.ly/gy7s30jS3r8 #OpenGovCan

Are you looking for information on a topic of interest? The #GC Publications website has free federal publications on a wide variety of topics. Read more about what we offer #Canadians and why it’s important: ow.ly/3kzc50KWUWn #OpenGovCan

"But more importantly, it’s about a lazy extension of crisis rules in Parliament that could lead to an erosion of accountability and a loss of some of the good things that get done in the public square." #opengovcan
Time to wind down the hybrid Parliament theglobeandmail.com/politics/artic…
lack of transparency of media subsidization program reported in Canada #opengovcan
They aren't telling. The names of the news organizations currently funded by taxpayers is a secret. The amounts they receive are a secret. The names of those rejected are a secret. The reasons why they were rejected are a secret. +
DYK that #Canada completed a pilot of the @opencontracting Data Standard? open.canada.ca/data/en/datase… PLUS a "lessons learned" document donnees-data.tpsgc-pwgsc.gc.ca/ba2/pilot-oc-p… They skipped publication of supplier IDs. Curious what folks in the #opengovcan community think about this pilot?
I now take this energy and join @JeanCard78 @karin_fuller @MelRobrt and team to work on something I advocate for passionately and relentlessly. I cannot wait to see where we take #OpenGovCan and where #OpenGov takes us. Ping me if you want to chat about any & all of this.
Great Tik Tok series re implementation progress of Canada’s Truth & Reconciliation commission: vm.tiktok.com/ZSJbq7WP7/ DYK that it’s hard to judge whether child welfare has improved due to a lack of a national harmonized data set? #opengovcan #cdnpoli #abpoli @cblackst
We recently added a new dataset to the #OpenGov Portal, on #FSWEP applications and referrals. Explore the dataset and learn more here: ow.ly/jB1M50FkcQe #OpenGovCan
💡🇨🇦 @OpenGovCan announced that the Canadian #OpenData Summit (CODS) is back in September 2021 & will be hosted virtually & bilingually by the City of Montreal & the Government of Quebec. open.canada.ca/en #OpenGov #OpenGovCan #GouvernementOuvert

ICYMI: The #OpenGovCan portal was updated with a new staffing dashboard visualization tool to give users a broader understanding of staffing in their organizations & in the #GC! Check it out: ow.ly/Zifu50F8xWe
CSE released its first Annual Public Report in 2020, but did you know that we also released our first Open Government Implementation Plan? Find it here: open.canada.ca/data/en/datase… #OpenGovCan #OpenGovWeek

#OpenGovWeek is a unique opportunity for Canadians to influence how government interacts with its citizens. Have your say by getting involved! Find out how: open.canada.ca/en/content/ope… #OpenGovCan

The RCMP is committed to enhancing transparency and trust as we head into #OpenGovWeek. Check out some of the great events planned by visiting the link in the post below. #OpenGovCan
It’s #OpenGovWeek and CSE is getting involved! #DYK? As part of our commitment to open government, we’ve published 187 datasets to the Government of Canada’s Open Government Portal – with more to come! #OpenGovCan open.canada.ca/data/en/datase…

At CSE, we are committed to being as open and transparent as we can be. That’s why we’re excited to be taking part in #OpenGovWeek this May 17 to 21. Learn more about it: open.canada.ca/en/content/ope… #OpenGovCan

The RCMP's new Analytics Data and Information Management Directorate is excited to participate in #OpenGovWeek from May 17– 21. Join us in checking out the upcoming events at the link below. #OpenGovCan
It’s a critical time for this critical conference. Help shape what it will offer and how to best access it at the link below. #gc #opengovcan
Kicking off the annual #FWD50 survey! We want to know what topics matter most to you, so we can deliver great content on vital themes. Invest 15 minutes of your day, so we have data to crunch, and can share the insights with you in a few weeks! bit.ly/30V8r5x

If your a Canadian, be sure to have your opinion heard on #OpenGovCan
You have no idea how proud I am of watching the #CanadaBeyond150 #opengovcan team present to their managers. Dans les deux langues en plus. This is what the next generation of public leaders look like:Open, inclusive, and curious! #proudpapa

In February's #CFIABulletin, we tested for viruses in sun-dried tomatoes. #OpenGovCan ow.ly/jbRF30iDX78

At #3GCDC with @LucBeal90 - come say hi 👋 and we’ll tell you about how #OpenGovCan is working to improve #opendata

Why test for Listeria monocytogenes in ready-to-eat (RTE) products? #CFIABulletin #OpenGovCan ow.ly/hUFC30iDX6O

Behind the scenes of our #FeministOpenGov webinar session - happening now! We’re getting lots of great questions. For those who are unable to join, we’ll be sharing a recording later 😊 #OpenGovCan

This is what success looks like. #CanadaBeyond150 #opengovcan team, conversing about the dynamic of navigating citizen engagement complicated by chatbots and troll factories with deputies and @Clerk_GC

Great day wrapping up the #OGPCanada Global Summit with our 4 #NationalSecurity panels. Today we discussed Declassification of Government Records, Oversight and Review Bodies, Transparency, and Democratic Values. Great discussions and questions! #OpenGovCan #OurNatlSec




Join the conversation on how citizens, civil society and government can better work together during #OpenGovWeek. See what Canada’s planning from May 7-11 by viewing the event calendar here: ow.ly/gy7s30jS3r8 #OpenGovCan

We’re plotting how #GoC employees perceive their organization’s data holdings. Come tell us what you think! #3GCDC #OpenGovCan

Join the conversation on how citizens, civil society and government can better work together during #OpenGovWeek. See what Canada’s planning from May 7-11 by viewing the event calendar here: open.canada.ca/en/content/ope… #OpenGovCan

Fantastic first day at the #OGPCanada Global Summit! Today we held a panel discussion on Collective Actions to Eradicate Online Terrorist and Violent Extremist Content and another on GBA+ & Diversity in #NationalSecurity. #OpenGovCan #OurNatlSec



In this month's #CFIABulletin, we tested for bacterial pathogens in cucumbers. ow.ly/uK3R30j4Ufl #CFIAScience #OpenGovCan

#OpenGovCan strategic retreat today! We created a timeline of our deliverables organized by level of importance. Apparently this will be translated into a doc of some sort. I'll find a way to share it for those that are interested in seeing what we're up to 😊#opengov


We are going to apply a gender lens to all of Canada’s draft Open Government Action Plan commitments. #OGPGeorgia #OpenGovCan

Something went wrong.
Something went wrong.
United States Trends
- 1. Cowboys 86.1K posts
- 2. Eagles 124K posts
- 3. Rams 21.2K posts
- 4. Stafford 9,135 posts
- 5. #BaddiesUSA 13.2K posts
- 6. Bucs 8,946 posts
- 7. Baker 16.6K posts
- 8. Scotty 5,626 posts
- 9. #RHOP 7,077 posts
- 10. Pickens 26.9K posts
- 11. Raiders 54.1K posts
- 12. Browns 97.9K posts
- 13. Stacey 29.6K posts
- 14. Todd Bowles 1,007 posts
- 15. Davante Adams 2,135 posts
- 16. Shedeur 111K posts
- 17. Nimmo 18.3K posts
- 18. Ceedee 16.3K posts
- 19. Patullo 11.6K posts
- 20. Saquon 7,492 posts